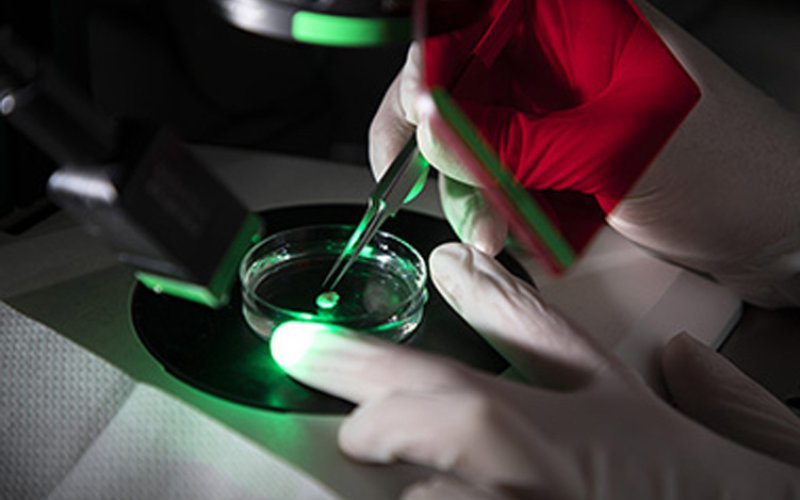

Research Division Confronts COVID-19, Providing Researchers with Guidance and Funding Opportunities
UAlbany is providing valuable and timely information on grant opportunities for researchers and scholars with expertise in a wide range of disciplines. (Photo by Patrick Dodson)
ALBANY, N.Y. (March 27, 2020) — Vice President for Research James Dias knows how important is the part being played by researchers in the world’s fight against COVID-19. That’s why he’s please to see the University and SUNY finding ways to offer guidance for these investigators and also to give them new sources for funded research into the pandemic virus.
“Public research universities, like ours, play a critical role in serving the public good, particularly during times of crisis,” said Dias. “In response to and in the aftermath of the COVID-19 global pandemic that has dramatically altered our everyday way of life, I am enormously proud of our faculty and researchers who are applying their research and scholarly talents to address the COVID-19 challenges facing society today.”
A special website, Research Guidance: COVID-19, now exists on the Division for Research website, that includes safe ways to access research spaces and labs and deal with vendor deliveries, find web resources and develop research continuity plans. The site also calls for questions from faculty that will be answered in an online conversation with the college and schools’ associate deans for research and center/lab directors on the current state of research on campus in relation to the COVID-19 outbreak.

“This site appears to have all the information that a researchers might look for,” said Satyendra Kumar, associate vice president for research in charge of grants development. “It is being updated as things change — and they are changing by the hour. This has been impressive teamwork that has proven to be effective, beyond my expectations, in helping our researchers, faculty, and students continue to perform their normal function to the extent possible.”
The division is also directing faculty to SUNY’s COVID-19 Funding Opportunities website, which provides valuable and timely information on grant opportunities for researchers and scholars with expertise in a wide range of disciplines, and includes invitations to apply for NSF's RAPID and NIH’s Urgent Award grants targeted at addressing the COVID-19 outbreak.
“As I look across the University — from our College of Arts and Sciences, to College of Emergency Preparedness, Homeland Security and Cybersecurity, to our School of Public Health and beyond — our faculty and researchers are once again being sought out for their expertise,” said Dias. “And they are rising to the occasion to serve our mission and meet perhaps the greatest public health challenge of the last century.
“In addition, our Centers — for example, those affiliated with the Rockefeller College and School of Social Welfare — have adapted to online formats to continue to provide critical training of human services providers and to evaluate the impact of those human services. The resilience of our community and the ability pivot whether in academic delivery, research services or training has been truly amazing.”




